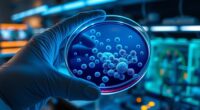
new antibiotic for resistant bacteria

You discover the ruins of an ancient Buddhist temple along the Silk Road, revealing intricate carvings and crumbling walls that tell stories of a vibrant past. As you explore, you’ll notice sophisticated medieval architecture with carefully fitted stones and decorative details reflecting diverse cultural influences. Artifacts like pottery shards and ritual objects shed light on religious practices and daily life. Continue exploring to uncover how this site links ancient craftsmanship, spiritual life, and regional history.
Key Takeaways
- The ruins reveal medieval architecture with intricate stone carvings, indicating a historic Buddhist place of worship along the Silk Road.
- Excavations uncovered artifacts like pottery, ritual objects, and statues, offering insights into religious practices and daily life.
- The site demonstrates sophisticated construction techniques, including carefully fitted stones and decorative elements reflecting cultural exchanges.
- Discoveries highlight the spread of Buddhism and its role in regional history, showcasing interactions between diverse civilizations.
- Preservation efforts emphasize the importance of these archaeological remains for understanding medieval craftsmanship and spiritual life.

Hidden amidst overgrown foliage, the ruins of the ancient Buddhist temple reveal a fascinating glimpse into a bygone era. As you explore the site, you notice the remnants of intricate stone carvings and crumbling walls that hint at a once-vibrant place of worship. These ruins are a testimony to the craftsmanship and spiritual significance of the period, offering a direct link to the past. During the archaeological excavation, experts uncovered foundations that date back centuries, revealing the sophisticated medieval architecture that defined this temple. The construction techniques used—such as carefully fitted stones and elaborate decorative elements—highlight the skill of the builders and their dedication to creating a sacred space that could withstand the test of time.
As you walk through the site, you can imagine the bustling activity that once filled these grounds. The archaeological excavation uncovered artifacts like pottery shards, ritual objects, and fragments of statues, all providing clues about the daily life and religious practices of those who worshipped here. The layout of the ruins suggests a complex structure, with evidence of courtyards, prayer halls, and perhaps even living quarters for monks or pilgrims. The medieval architecture visible in the remaining walls reflects the diverse influences that traveled along the Silk Road, blending local craftsmanship with broader cultural exchanges. You realize that this site was not just a religious center but also a hub of cultural interaction, where ideas, art, and trade converged. Additionally, the preservation of these ruins helps us understand the spread of Buddhism and its role in shaping regional history.
The excavation process itself is meticulous and revealing. Each new discovery sheds light on how the temple was built and used, allowing archaeologists to piece together the story of its construction and subsequent abandonment. The layers of earth and debris tell a story of natural and human events that have shaped the site over centuries. As you stand amidst the ruins, you can appreciate the importance of preserving these remnants, which serve as invaluable archaeological evidence. They help us understand the spread of Buddhism along the Silk Road and the architectural innovations of the medieval period. This site is more than just broken stones; it’s a window into a vibrant past, offering insights into the spiritual and cultural life of a distant civilization, all uncovered through careful excavation and scholarly study.

Sands3D™ Parthenon Model – Miniature Greek Temple Replica, Ancient Architecture Display, Classical Landmark Collectible
🏛️ Exquisite Parthenon Replica – A beautifully crafted miniature of the historic Greek Parthenon, showcasing its iconic columns…
As an affiliate, we earn on qualifying purchases.
As an affiliate, we earn on qualifying purchases.
Frequently Asked Questions
How Old Is the Temple Site?
The temple site is approximately 1,500 years old, based on archaeological dating. You can see how its architecture reflects the style of ancient Buddhist structures, with intricate carvings and unique design elements. This discovery offers a glimpse into the past, revealing how temple architecture evolved over centuries. As you explore, you’ll appreciate the historical significance, understanding that this site has stood for centuries, connecting you to ancient traditions and cultural heritage.
Were Any Artifacts Recovered From the Ruins?
You’ll be amazed—artifacts recovered from the ruins are truly priceless, offering incredible insights into ancient life. The excavation techniques used helped uncover delicate objects that hold immense artifact significance, revealing details about the temple’s history and culture. These finds include pottery, religious items, and inscriptions, each telling a story. Your discovery journey highlights how careful digging and modern tools reveal secrets buried deep for centuries, making history come alive.
Which Dynasty or Period Does the Temple Belong To?
You can identify the dynasty of this ancient Buddhist temple by examining its architecture and artifacts, which reflect the historical context of its time. Based on the style and materials, it likely belongs to the Tang Dynasty, known for flourishing Buddhism along the Silk Road. This dynasty’s influence is evident in the temple’s design and inscriptions, helping you understand its historical significance and the cultural exchange during that period.
What Specific Buddhist Sect Was Practiced There?
You discover that the temple practiced Mahayana Buddhism, evident from the sectarian practices and ritual artifacts found on-site. These artifacts, including statues and ritual tools, reveal a focus on compassion and universal salvation characteristic of Mahayana. The temple’s layout and relics suggest rituals aimed at enlightenment and devotion, offering insight into the spiritual life of its practitioners and highlighting its importance along the Silk Road’s religious landscape.
Are There Plans for Further Excavation or Preservation?
Imagine opening secrets buried beneath time—yes, there are plans for future excavation and preservation. You’ll see experts employing advanced conservation strategies to protect this priceless site. Future excavation plans aim to uncover more artifacts and details about the temple’s history. With careful preservation, you can help guarantee this cultural treasure endures, inviting future generations to experience its ancient wonder and deepen their understanding of Silk Road history.
Silk Road archaeological artifact display
As an affiliate, we earn on qualifying purchases.
As an affiliate, we earn on qualifying purchases.
Conclusion
Like uncovering a hidden chapter of a long-forgotten story, these ruins remind you that history’s whispers still echo through time. Each stone, weathered yet resilient, invites you to reflect on the enduring spirit of faith and connection. Just as the Silk Road once wove diverse worlds together, these relics symbolize the timeless journey of discovery and unity. In uncovering the past, you’re reminded that history’s lessons are the bridges guiding us forward.

MiniCity DIY Book Nook Kit – The Castle's Escape 3D Miniature Wooden Scene with LED Lights, Dustcover & Tools for Shelf Decor (Robin Hood)
MiniCity Book Nook Kit: Our design draws its soul from the timeless legend of Robin Hood, a symbol…
As an affiliate, we earn on qualifying purchases.
As an affiliate, we earn on qualifying purchases.

Dharma Objects Tibetan Buddhist Meditation Om Mane Padme Hum Bell and Dorje Set
Sacred Meditation Set: Complete traditional Tibetan Buddhist ritual set featuring an authentic bell (Ghanta) and dorje (Vajra) designed…
As an affiliate, we earn on qualifying purchases.
As an affiliate, we earn on qualifying purchases.